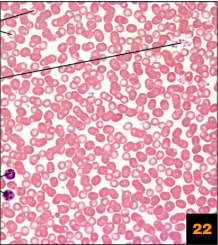
term image
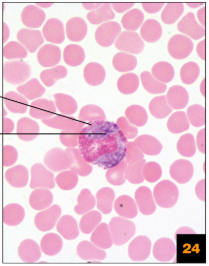
term image
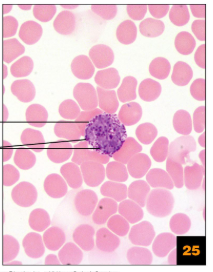
term image
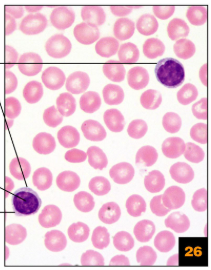
term image
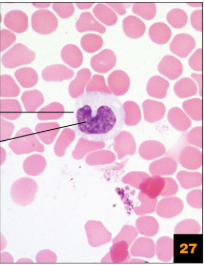
term image

Anatomy and Physiology 1st Sem Practical Final
1/348
There's no tags or description
Looks like no tags are added yet.
Name | Mastery | Learn | Test | Matching | Spaced |
|---|
No study sessions yet.
349 Terms

E
Anterior

G
Deep

B
Distal

M
Inferior
Intermediate

D
Lateral

C
Medial

I
Posterior

A
Proximal

F
Superficial

N
Superior

I
Frontal/Coronal

II
Sagittal

III
Transverse

I
Abdominal

F
Acromial

i
Antebrachial

L
Antecubital

N
Axillary

M
Brachial

J
Calcaneal

n
Carpal

Q
Cephalic

F
Cervical
Coxal

c
Crural

e
Digital

X
Femoral
Fibular

A
Frontal

M
Gluteal

v
Inguinal

N
Lumbar

H
Mammary

U
Manus

O
Mental
Metacarpal
Metatarsal

B
Nasal
Occipital

P
Oral

C
Orbital

D
Otic

g
Palmar

d
Patellar

Y
Pedal

I
Plantar

L
Popliteal

W
Pubic
Sacral
Scapular
Sternal

K
Sural

G
Thoracic

J
Umbilical
Vertebral

A
Epigastric region

C
hypogastric region

G
left hypochondriac region

D
right hypochondriac region

I
left iliac region

F
right iliac region

H
left lumbar region

E
right lumbar region

B
umbilical region

E
Abdominal Cavity

D,E,&F
abdominopelvic cavity

A
cranial cavity

B
dorsal body cavity

B
pericardial cavity

F
pelvic cavity

A
pleural cavity

A & B
thoracic cavity

H
Ventral body cavity

C
vertebral cavity

Adipose Tissue
blood tissue

cardiac muscle tissue

dense irregular connective tissue

dense regular connective tissue

fibrocartilage

hyaline cartilage

nervous tissue

bone/osseous tissue

pseudostratified columnar epthelium

simple columnar epithelium

simple cuboidal epithelium

simple squamous epithelium

skeletal muscle tissue

smooth muscle tissue

stratified squamous epithelium

Adipose tissue

blood tissue
blood tissue
blood tissue
blood tissue
blood tissue

cardiac muscle tissue

cardiac muscle tissue

dense irregular connective tissue